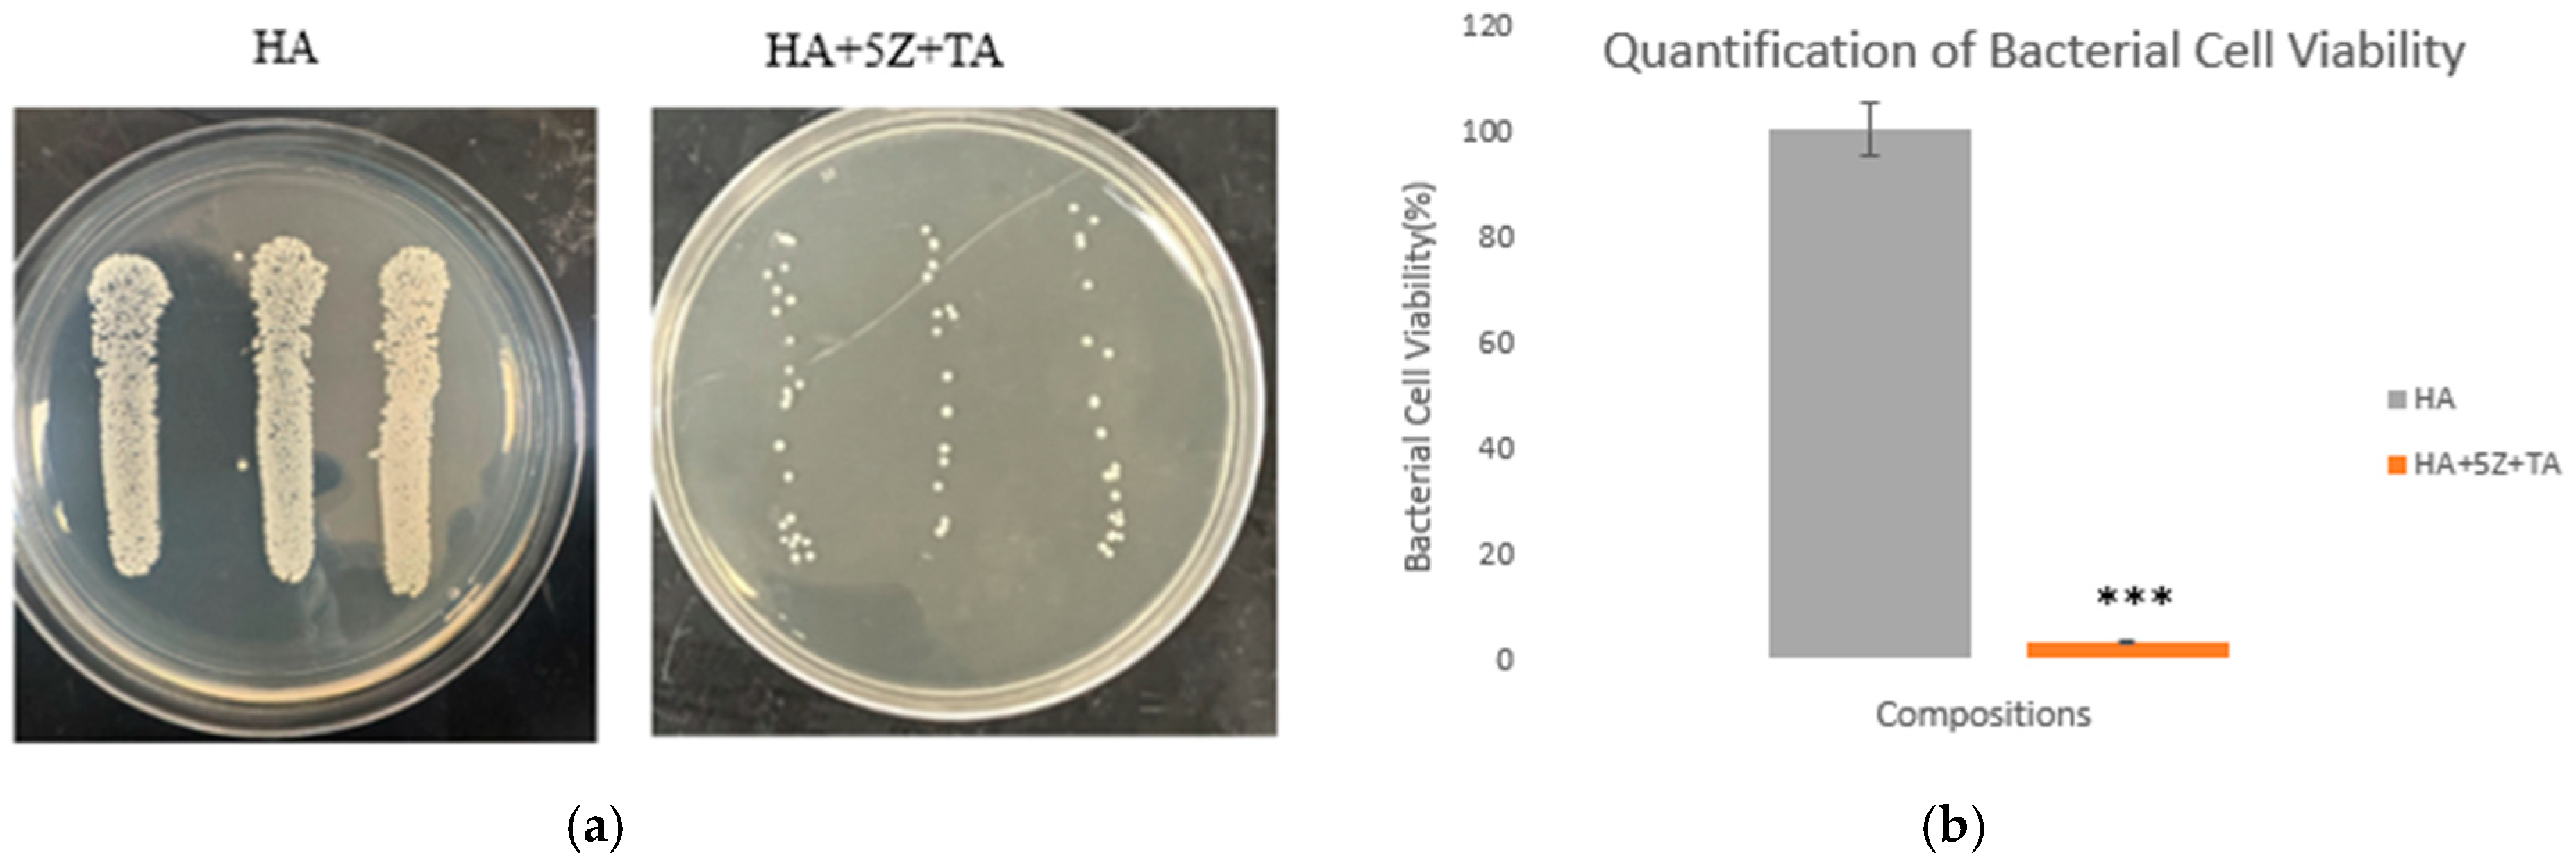
Crystals 15 00396 g007

Tannic Acid-Loaded Antibacterial Hydroxyapatite-Zirconia Composite for Dental Applications
Abstract
:1. Introduction
2. Materials and Methods
2.1. Sample Preparation
2.2. Assessment of Densification and Dimensional Shrinkage
2.3. Analysis of Phase and Microstructure
2.4. Assessment of Mechanical Properties
2.5. Tannic Acid Loading and Characterization
2.6. Antibacterial Efficacy Assessment
2.6.1. Modified ISO 22196:2011 Standard
2.6.2. Morphological Characterization
2.7. Assessment of Cytocompatibility
2.7.1. Cell Seeding on the Sample Surfaces
2.7.2. Cell Viability Quantification by MTT Assay
3. Results
4. Discussion
4.1. Natural Medicinal Compounds as an Alternative Drug
4.1.1. HA-Zirconia Composite for Bone Tissue Engineering
4.1.2. Clinical Significance of Antibacterial Scaffolds
4.1.3. The Function of Tannic Acid Loaded HA-Zirconia Graft
4.1.4. Contributions to Science and Direction to Future Research
5. Conclusions
Author Contributions
Funding
Data Availability Statement
Acknowledgments
Conflicts of Interest
References
- Henkel, J.; Woodruff, M.; Epari, D.; Steck, R.; Glatt, V.; Dickinson, I.C.; Choong, P.; Schuetz, M.A.; Hutmacher, D.W. Bone Regeneration Based on Tissue Engineering Conceptions—A 21st Century Perspective. Bone Res. 2013, 1, 216–248. [Google Scholar] [CrossRef] [PubMed]
- Putelli, C.; Pilli, J.; Gatto, G.; Bhattacharjee, A. Tannic Acid-Loaded MgO and ZnO-Doped Antibacterial Hydroxyapatite for Orthopedic and Dental Applications. JOM 2024, 76, 5703–5712. [Google Scholar] [CrossRef]
- Sarkar, N.; Bose, S. Controlled Delivery of Curcumin and Vitamin K2 from Hydroxyapatite-Coated Titanium Implant for Enhanced in Vitro Chemoprevention, Osteogenesis, and in Vivo Osseointegration. ACS Appl. Mater. Interfaces 2020, 12, 13644–13656. [Google Scholar] [CrossRef] [PubMed]
- Luetke, A.; Meyers, P.A.; Lewis, I.; Juergens, H. Osteosarcoma treatment—Where do we stand? A state of the art review. Cancer Treat. Rev. 2014, 40, 523–532. [Google Scholar] [CrossRef]
- Sanyal, V.; Raja, C.R. Structural and antibacterial activity of hydroxyapatite and fluorohydroxyapatite co-substituted with zirconium–cerium ions. Appl. Phys. A 2016, 122, 132. [Google Scholar] [CrossRef]
- Lee, S.W.; Phillips, K.S.; Gu, H.; Kazemzadeh-Narbat, M.; Ren, D. How microbes read the map: Effects of implant topography on bacterial adhesion and biofilm formation. Biomaterials 2021, 268, 120595. [Google Scholar] [CrossRef]
- Chin, M.Y.; Sandham, A.; de Vries, J.; van der Mei, H.C.; Busscher, H.J. Biofilm formation on surface characterized micro-implants for skeletal anchorage in orthodontics. Biomaterials 2007, 28, 2032–2040. [Google Scholar] [CrossRef]
- Barman, S.; Kurnaz, L.B.; Leighton, R.; Hossain, W.; Decho, A.W.; Tang, C. Intrinsic antimicrobial resistance: Molecular biomaterials to combat microbial biofilms and bacterial persisters. Biomaterials 2024, 311, 122690. [Google Scholar] [CrossRef]
- Jain, N.; Dutt, U.; Radenkov, I.; Jain, S. WHO’s global oral health status report 2022: Actions, discussion and implementation. Oral Dis. 2023, 30, 73–79. [Google Scholar] [CrossRef]
- Al Saad, A.; Sikder, P.; Bhaduri, S.B. Ceria-Stabilized Tetragonal Zirconia Polycrystal (Ce-TZP) as Low-Temperature Degradation (LTD) Resistant Dental Biomaterial. n.d. Available online: https://ssrn.com/abstract=4515792 (accessed on 30 September 2024).
- Jiang, X.; Yao, Y.; Tang, W.; Han, D.; Zhang, L.; Zhao, K.; Wang, S.; Meng, Y. Design of dental implants at materials level: An overview. J. Biomed. Mater. Res. Part A 2020, 108, 1634–1661. [Google Scholar] [CrossRef]
- Narayan, R. Biomedical Materials; Springer: Berlin/Heidelberg, Germany, 2009. [Google Scholar] [CrossRef]
- Ekambaram, R.; Paraman, V.; Raja, L.; Suresh, M.K.; Dharmalingam, S. Design and development of electrospun SPEEK incorporated with aminated zirconia and curcumin nanofibers for periodontal regeneration. J. Mech. Behav. Biomed. Mater. 2021, 123, 104796. [Google Scholar] [CrossRef] [PubMed]
- Erkmen, Z.E.; Genç, Y.; Oktar, F.N. Microstructural and Mechanical Properties of Hydroxyapatite–Zirconia Composites. J. Am. Ceram. Soc. 2007, 90, 2885–2892. [Google Scholar] [CrossRef]
- Ferreira, C.; Santiago, A.; Vasconcelos, R.; Paiva, D.; Pirih, F.; Araújo, A.; Motta, F.; Bomio, M. Study of microstructural, mechanical, and biomedical properties of zirconia/hydroxyapatite ceramic composites. Ceram. Int. 2022, 48, 12376–12386. [Google Scholar] [CrossRef]
- Boanini, E.; Gazzano, M.; Bigi, A. Ionic substitutions in calcium phosphates synthesized at low temperature. Acta Biomater. 2010, 6, 1882–1894. [Google Scholar] [CrossRef]
- Khurshid, Z.; Zafar, M.; Qasim, S.; Shahab, S.; Naseem, M.; AbuReqaiba, A. Advances in Nanotechnology for Restorative Dentistry. Materials 2015, 8, 717–731. [Google Scholar] [CrossRef]
- Bollino, F.; Armenia, E.; Tranquillo, E. Zirconia/Hydroxyapatite Composites Synthesized Via Sol-Gel: Influence of Hydroxyapatite Content and Heating on Their Biological Properties. Materials 2017, 10, 757. [Google Scholar] [CrossRef]
- Silva, V.V.; Domingues, R.Z.; Lameiras, F.S. Microstructural and mechanical study of zirconia-hydroxyapatite (ZH) composite ceramics for biomedical applications. Compos. Sci. Technol. 2001, 61, 301–310. [Google Scholar] [CrossRef]
- Rao, R.R.; Kannan, T. Synthesis and sintering of hydroxyapatite–zirconia composites. Mater. Sci. Eng. C 2002, 20, 187–193. [Google Scholar] [CrossRef]
- Sung, Y.-M.; Shin, Y.-K.; Ryu, J.-J. Preparation of hydroxyapatite/zirconia bioceramic nanocomposites for orthopaedic and dental prosthesis applications. Nanotechnology 2007, 18, 065602. [Google Scholar] [CrossRef]
- Sivaperumal, V.R.; Mani, R.; Polisetti, V.; Aruchamy, K.; Oh, T. Synthesis of Hydroxyapatite (HAp)-Zirconia Nanocomposite Powder and Evaluation of Its Biocompatibility: An In Vitro Study. Appl. Sci. 2022, 12, 11056. [Google Scholar] [CrossRef]
- Dabbaghi, A.; Kabiri, K.; Ramazani, A.; Zohuriaan-Mehr, M.J.; Jahandideh, A. Synthesis of bio-based internal and external cross-linkers based on tannic acid for preparation of antibacterial superabsorbents. Polym. Adv. Technol. 2019, 30, 2894–2905. [Google Scholar] [CrossRef]
- Ke, D.; Vu, A.A.; Bandyopadhyay, A.; Bose, S. Compositionally graded doped hydroxyapatite coating on titanium using laser and plasma spray deposition for bone implants. Acta Biomater. 2019, 84, 414–423. [Google Scholar] [CrossRef]
- Bhattacharjee, A.; Gupta, A.; Verma, M.; Murugan, P.A.; Sengupta, P.; Matheshwaran, S.; Manna, I.; Balani, K. Site-specific antibacterial efficacy and cyto/hemo-compatibility of zinc substituted hydroxyapatite. Ceram. Int. 2019, 45, 12225–12233. [Google Scholar] [CrossRef]
- Gomes, S.; Nedelec, J.-M.; Renaudin, G. On the effect of temperature on the insertion of zinc into hydroxyapatite. Acta Biomater. 2012, 8, 1180–1189. [Google Scholar] [CrossRef]
- Tarafder, S.; Balla, V.K.; Davies, N.M.; Bandyopadhyay, A.; Bose, S. Microwave-sintered 3D printed tricalcium phosphate scaffolds for bone tissue engineering. J. Tissue Eng. Regen. Med. 2012, 7, 631–641. [Google Scholar] [CrossRef]
- Bhattacharjee, A.; Bose, S. Multifunctional polydopamine—Zn2+-curcumin coated additively manufactured ceramic bone grafts with enhanced biological properties. Mater. Sci. Eng. C 2023, 153, 213487. [Google Scholar] [CrossRef] [PubMed]
- Bhattacharjee, A.; Jo, Y.; Bose, S. In vivo and In vitro properties evaluation of curcumin loaded MgO doped 3D printed TCP scaffolds. J. Mater. Chem. B 2023, 11, 4725–4739. [Google Scholar] [CrossRef]
- Bhattacharjee, A.; Bose, S. 3D printed hydroxyapatite–Zn2+ functionalized starch composite bone grafts for orthopedic and dental applications. Mater. Des. 2022, 221, 110903. [Google Scholar] [CrossRef]
- Bhattacharjee, A.; Gupta, A.; Verma, M.; Anand, M.P.; Sengupta, P.; Saravanan, M.; Manna, I.; Balani, K. Antibacterial and magnetic response of site-specific cobalt incorporated hydroxyapatite. Ceram. Int. 2020, 46, 513–522. [Google Scholar] [CrossRef]
- Boga, J.C.; Miguel, S.P.; de Melo-Diogo, D.; Mendonça, A.G.; Louro, R.O.; Correia, I.J. In vitro characterization of 3D printed scaffolds aimed at bone tissue regeneration. Colloids Surf. B Biointerfaces 2018, 165, 207–218. [Google Scholar] [CrossRef]
- Fiore, N.J.; Tamer-Mahoney, J.D.; Beheshti, A.; Nieland, T.J.; Kaplan, D.L. 3D biocomposite culture enhances differentiation of dopamine-like neurons from SH-SY5Y cells: A model for studying Parkinson’s disease phenotypes. Biomaterials 2022, 290, 121858. [Google Scholar] [CrossRef] [PubMed]
- Fu, L.; Khor, K.A.; Lim, J.P. Yttria stabilized zirconia reinforced hydroxyapatite coatings. Surf. Coat. Technol. 2000, 127, 66–75. [Google Scholar] [CrossRef]
- Kumar, K.V.; Subha, T.J.; Ahila, K.; Ravindran, B.; Chang, S.; Mahmoud, A.H.; Mohammed, O.B.; Rathi, M. Spectral characterization of hydroxyapatite extracted from Black Sumatra and Fighting cock bone samples: A comparative analysis. Saudi J. Biol. Sci. 2021, 28, 840–846. [Google Scholar] [CrossRef]
- Teixeira, S.; Rodriguez, M.; Pena, P.; De Aza, A.; De Aza, S.; Ferraz, M.; Monteiro, F. Physical characterization of hydroxyapatite porous scaffolds for tissue engineering. Mater. Sci. Eng. C 2008, 29, 1510–1514. [Google Scholar] [CrossRef]
- Prema, D.; Gnanavel, S.; Anuraj, S.; Gopalakrishnan, C. Synthesis and Characterization of Different Chemical Combination of Hydroxyapatite for Biomedical Application. 2018. Available online: www.sciencedirect.com (accessed on 15 October 2024).
- Mansour, S.F.; El-Dek, S.I.; Ahmed, M.K. Physico-mechanical and morphological features of zirconia substituted hydroxyapatite nano crystals. Sci. Rep. 2017, 7, 43202. [Google Scholar] [CrossRef]
- Ling, Y.; Li, Q.; Zheng, H.; Omran, M.; Gao, L.; Chen, J.; Chen, G. Optimisation on the stability of CaO-doped partially stabilised zirconia by microwave heating. Ceram. Int. 2021, 47, 8067–8074. [Google Scholar] [CrossRef]
- Balamurugan, A.; Balossier, G.; Kannan, S.; Michel, J.; Faure, J.; Rajeswari, S. Electrochemical and structural characterisation of zirconia reinforced hydroxyapatite bioceramic sol–gel coatings on surgical grade 316L SS for biomedical applications. Ceram. Int. 2007, 33, 605–614. [Google Scholar] [CrossRef]
- Bhattacharjee, A.; Hassan, R.; Gupta, A.; Verma, M.; Murugan, P.A.; Sengupta, P.; Saravanan, M.; Manna, I.; Balani, K. Effect of Zn and Co doping on antibacterial efficacy and cytocompatibility of spark plasma sintered hydroxyapatite. J. Am. Ceram. Soc. 2020, 103, 4090–4100. [Google Scholar] [CrossRef]
- Hoepfner, T.P.; Case, E. The influence of the microstructure on the hardness of sintered hydroxyapatite. Ceram. Int. 2003, 29, 699–706. [Google Scholar] [CrossRef]
- Gibson, I.R.; Best, S.M.; Bonfield, W. Effect of Silicon Substitution on the Sintering and Microstructure of Hydroxyapatite. J. Am. Ceram. Soc. 2002, 85, 2771–2777. [Google Scholar] [CrossRef]
- Oliveira, L.C.C.; Rodrigues, F.A.A.; Barbosa, C.R.d.S.; dos Santos, J.F.S.; Macêdo, N.S.; Silveira, Z.d.S.; Coutinho, H.D.M.; da Cunha, F.A.B. Antibacterial Activity of the Pyrogallol against Staphylococcus aureus Evaluated by Optical Image. Biologics 2022, 2, 139–150. [Google Scholar] [CrossRef]
- Zhang, C.; Wei, S.; Hu, Y.; Tang, H.; Gao, J.; Yin, Z.; Guan, Q. Selective adsorption of tannic acid on calcite and implications for separation of fluorite minerals. J. Colloid Interface Sci. 2018, 512, 55–63. [Google Scholar] [CrossRef] [PubMed]
- Son, H.Y.; Jun, H.; Kim, K.R.; Hong, C.A.; Nam, Y.S. Tannin-mediated assembly of gold–titanium oxide hybrid nanoparticles for plasmonic photochemical applications. J. Ind. Eng. Chem. 2018, 63, 420–425. [Google Scholar] [CrossRef]
- Ke, D.; Tarafder, S.; Vahabzadeh, S.; Bose, S. Effects of MgO, ZnO, SrO, and SiO2 in tricalcium phosphate scaffolds on in vitro gene expression and in vivo osteogenesis. Mater. Sci. Eng. C 2019, 96, 10–19. [Google Scholar] [CrossRef] [PubMed]
- Gopi, D.; Ramya, S.; Rajeswari, D.; Karthikeyan, P.; Kavitha, L. Strontium, cerium co-substituted hydroxyapatite nanoparticles: Synthesis, characterization, antibacterial activity towards prokaryotic strains and in vitro studies. Colloids Surf. A Physicochem. Eng. Asp. 2014, 451, 172–180. [Google Scholar] [CrossRef]
- Chen, Y.; Dong, Z.; Miao, X. The Effect of Yttria-Stabilized Zirconia on the Properties of the Fluorine-Substituted Hydroxyapatite Ceramics Prepared by Pressureless Sintering. J. Biomim. Biomater. Tissue Eng. 2008, 1, 57–68. [Google Scholar] [CrossRef]
- Predoi, D.; Iconaru, S.L.; Deniaud, A.; Chevallet, M.; Michaud-Soret, I.; Buton, N.; Prodan, A.M. Textural, Structural and Biological Evaluation of Hydroxyapatite Doped with Zinc at Low Concentrations. Materials 2017, 10, 229. [Google Scholar] [CrossRef]
- Ahn, E.S.; Gleason, N.J.; Ying, J.Y. The Effect of Zirconia Reinforcing Agents on the Microstructure and Mechanical Properties of Hydroxyapatite-Based Nanocomposites. J. Am. Ceram. Soc. 2005, 88, 3374–3379. [Google Scholar] [CrossRef]
- Kalita, S.J.; Bhatt, H.A. Nanocrystalline hydroxyapatite doped with magnesium and zinc: Synthesis and characterization. Mater. Sci. Eng. C 2007, 27, 837–848. [Google Scholar] [CrossRef]
- Evis, Z. Reactions in hydroxylapatite–zirconia composites. Ceram. Int. 2007, 33, 987–991. [Google Scholar] [CrossRef]
- Nayak, Y.; Rana, R.P.; Pratihar, S.K.; Bhattacharyya, S. Pressureless sintering of dense hydroxyapatite–zirconia composites. J. Mater. Sci. Mater. Med. 2008, 19, 2437–2444. [Google Scholar] [CrossRef] [PubMed]
- Masters, E.A.; Ricciardi, B.F.; Bentley, K.L.d.M.; Moriarty, T.F.; Schwarz, E.M.; Muthukrishnan, G. Skeletal infections: Microbial pathogenesis, immunity and clinical management. Nat. Rev. Microbiol. 2022, 20, 385–400. [Google Scholar] [CrossRef]
- Zhang, J.; Tu, J.; Chen, Y.; Jin, X. Clinical characteristics and homology analysis of Staphylococcus aureus from would infection at a tertiary hospital in southern Zhejiang, China. BMC Microbiol. 2023, 23, 1–15. [Google Scholar] [CrossRef] [PubMed]
- Biondo, C. Bacterial Antibiotic Resistance: The Most Critical Pathogens. Pathogens 2023, 12, 116. [Google Scholar] [CrossRef] [PubMed]
- Kaczmarek, B. Tannic acid with antiviral and antibacterial activity as a promising component of biomaterials—A minireview. Materials. 2020, 13, 3224. [Google Scholar] [CrossRef]
- Pandey, A.; Negi, P.S. Phytochemical composition, in vitro antioxidant activity and antibacterial mechanisms of Neolamarckia cadamba fruits extracts. Nat. Prod. Res. 2017, 32, 1189–1192. [Google Scholar] [CrossRef]
- Zeng, W.; Yu, W.; Shen, J.; Chen, P.; Shi, Z.; Xie, G.; Zhang, Y.; Wang, H.; Guo, N. Tannic Acid-Inspired antibacterial hydrogel with antioxidant and anti-inflammatory properties for Staphylococcus aureus-infected wound healing. Eur. Polym. J. 2023, 198, 112425. [Google Scholar] [CrossRef]
- Kumar, N.; Goel, N. Phenolic acids: Natural versatile molecules with promising therapeutic applications. Biotechnol. Rep. 2019, 24, e00370. [Google Scholar] [CrossRef]
- Bouki, E.; Dimitriadis, V.K.; Kaloyianni, M.; Dailianis, S. Antioxidant and pro-oxidant challenge of tannic acid in mussel hemocytes exposed to cadmium. Mar. Environ. Res. 2013, 85, 13–20. [Google Scholar] [CrossRef]
- Kim, T.; Silva, J.; Kim, M.; Jung, Y. Enhanced antioxidant capacity and antimicrobial activity of tannic acid by thermal processing. Food Chem. 2010, 118, 740–746. [Google Scholar] [CrossRef]
- Fu, Z.; Chen, R. Study of Complexes of Tannic Acid with Fe(III) and Fe(II). J. Anal. Methods Chem. 2019, 2019, 3894571. [Google Scholar] [CrossRef] [PubMed]

| Sample ID | Bulk Density (g/cm3) | Volume Shrinkage (%) | Radial Shrinkage (%) | Longitudinal Shrinkage (%) |
|---|---|---|---|---|
| HA | 2.66 | 55.67 | 23.75 | 21.78 |
| HA+5Z | 2.72 | 57.77 | 24.97 | 24.48 |
| HA+20Z | 2.03 | 42.73 | 16.96 | 16.39 |
Disclaimer/Publisher’s Note: The statements, opinions and data contained in all publications are solely those of the individual author(s) and contributor(s) and not of MDPI and/or the editor(s). MDPI and/or the editor(s) disclaim responsibility for any injury to people or property resulting from any ideas, methods, instructions or products referred to in the content. |
© 2025 by the authors. Licensee MDPI, Basel, Switzerland. This article is an open access article distributed under the terms and conditions of the Creative Commons Attribution (CC BY) license (https://creativecommons.org/licenses/by/4.0/).
Share and Cite
Yeasmin, N.; Pilli, J.; McWilliams, J.; Norris, S.; Bhattacharjee, A. Tannic Acid-Loaded Antibacterial Hydroxyapatite-Zirconia Composite for Dental Applications. Crystals 2025, 15, 396. https://doi.org/10.3390/cryst15050396
Yeasmin N, Pilli J, McWilliams J, Norris S, Bhattacharjee A. Tannic Acid-Loaded Antibacterial Hydroxyapatite-Zirconia Composite for Dental Applications. Crystals. 2025; 15(5):396. https://doi.org/10.3390/cryst15050396
Chicago/Turabian StyleYeasmin, Nusrat, Joel Pilli, Julian McWilliams, Sarah Norris, and Arjak Bhattacharjee. 2025. "Tannic Acid-Loaded Antibacterial Hydroxyapatite-Zirconia Composite for Dental Applications" Crystals 15, no. 5: 396. https://doi.org/10.3390/cryst15050396
APA StyleYeasmin, N., Pilli, J., McWilliams, J., Norris, S., & Bhattacharjee, A. (2025). Tannic Acid-Loaded Antibacterial Hydroxyapatite-Zirconia Composite for Dental Applications. Crystals, 15(5), 396. https://doi.org/10.3390/cryst15050396





